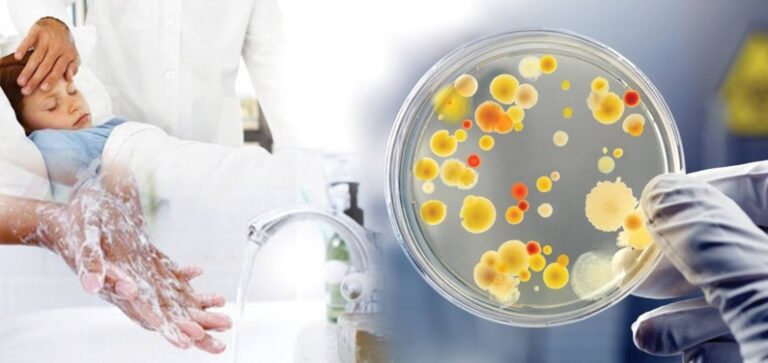
salmon2023

Рубрика Здоровый образ жизни


Всемирный день донора крови 2023

ПРИЛОЖЕНИЕ «ПО РАННЕЙ ДИАГНОСТИКЕ РАССТРОЙСТВ АУТИСТИЧЕСКОГО СПЕКТРА В АМБУЛАТОРНО-ПОЛИКЛИНИЧЕСКИХ ОРГАНИЗАЦИЯХ ЗДРАВООХРАНЕНИЯ»

Птичий грипп

31 мая — Всемирный день без табака

25 мая — Всемирный день щитовидной железы

Стартовала в Беларуси профилактическая акция «Декада кибербезопасности»

В период с 22 по 26 мая 2023 года в Витебской области пройдет акция «Профилактика меланомы и рака кожи»
Эпидемиологическая ситуация и меры профилактики сальмонеллеза
Профилактика сексуального насилия

МЕЖДУНАРОДНЫЙ ДЕНЬ ПАМЯТИ ЛЮДЕЙ, УМЕРШИХ ОТ СПИДА

